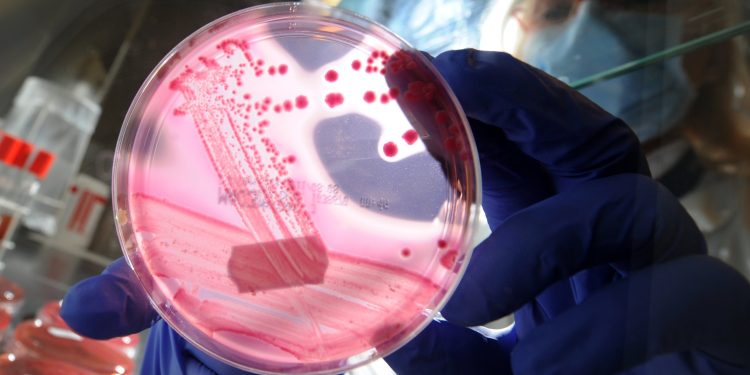
Resistência Microbiana: A Ameaça Global à Saúde

No Brasil, os óbitos associados à resistência microbiana são escassos, parte disso em razão da falta de notificação dos serviços de hospitais privados.
Resumo: As infecções hospitalares e a resistência antimicrobiana estão se tornando um problema global de saúde, com milhares de mortes relacionadas a bactérias resistentes aos medicamentos. A Organização Mundial da Saúde (OMS) emitiu um alerta sobre as “superbactérias” e sua ameaça à saúde pública, superando até mesmo as mortes por malária e HIV. No Brasil, a notificação de óbitos relacionados à resistência microbiana é escassa, devido à relutância dos hospitais privados em fornecer essas informações. A Agência Nacional de Vigilância Sanitária (Anvisa) monitora as infecções relacionadas à assistência à saúde e a resistência a antimicrobianos no país. No entanto, nos últimos três anos da pandemia, houve um aumento nos casos notificados. A prevenção e o controle dessas infecções são essenciais, com foco em programas de qualidade e protocolos de administração adequados de antibióticos. Além disso, é crucial que haja um esforço global para pesquisa e desenvolvimento de novos antibióticos, já que a falta de investimento nessa área é uma preocupação. Crianças e idosos são os grupos mais vulneráveis a infecções por superbactérias, tornando a resistência microbiana uma questão crítica de saúde pública.